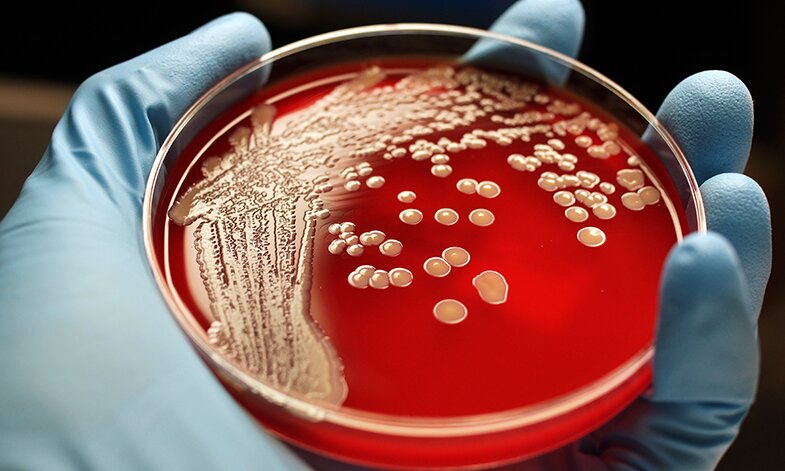

Researchers Create Novel Compound Effectively Eliminating Both Types of Antibiotic-Resistant Superbugs
A new compound has been developed by researchers at the University of Sheffield that has the ability to eliminate antibiotic-resistant bacteria, both gram-positive and gram-negative.
Gram-positive and gram-negative bacteria have different cell wall structures, but this new antibiotic compound can penetrate the cell wall of both types of bacteria and bind to their DNA.
The findings, which have been published in Chemical Science, open up possibilities for the development of new treatments for various antibiotic-resistant bacteria, including MRSA (gram-positive) and E.Coli (gram-negative).
Previously, the University of Sheffield team had developed compound leads that specifically targeted gram-negative bacteria. However, this new compound is a broad spectrum antimicrobial, meaning it is equally effective against both types of bacteria.
Treating gram-negative bacteria strains is particularly challenging due to their cell wall, which prevents drugs from entering the microbe. These bacteria can cause infections such as pneumonia, urinary tract infections, and bloodstream infections.
The research team collaborated with colleagues at the Science and Technology Facilities Council’s (STFC) Rutherford Appleton Laboratory (RAL).
Professor Jim Thomas, the Principal Investigator of the research at the University of Sheffield, stated, “Antimicrobial resistance is a growing problem, with many studies predicting a global medical emergency. Therefore, there is an urgent need for broad spectrum antimicrobials that can combat resistant pathogens. The luminescent nature of this compound allows us to track its uptake and impact on bacteria using advanced microscopy techniques available at STFC’s Rutherford Appleton Lab.”
Antimicrobial resistance already accounts for 25,000 deaths annually in the EU. If this rapidly emerging threat is not addressed, it is estimated that by 2050, over 10 million people could die each year due to antibiotic-resistant infections.
Doctors have not had a new treatment for gram-negative bacteria in the last 50 years, and no potential drugs have entered clinical trials since 2010.
This article is republished from PhysORG under a Creative Commons license. Read the original article.
Do not forget to share your opinion with us to provide you with the best posts !




0 Comments